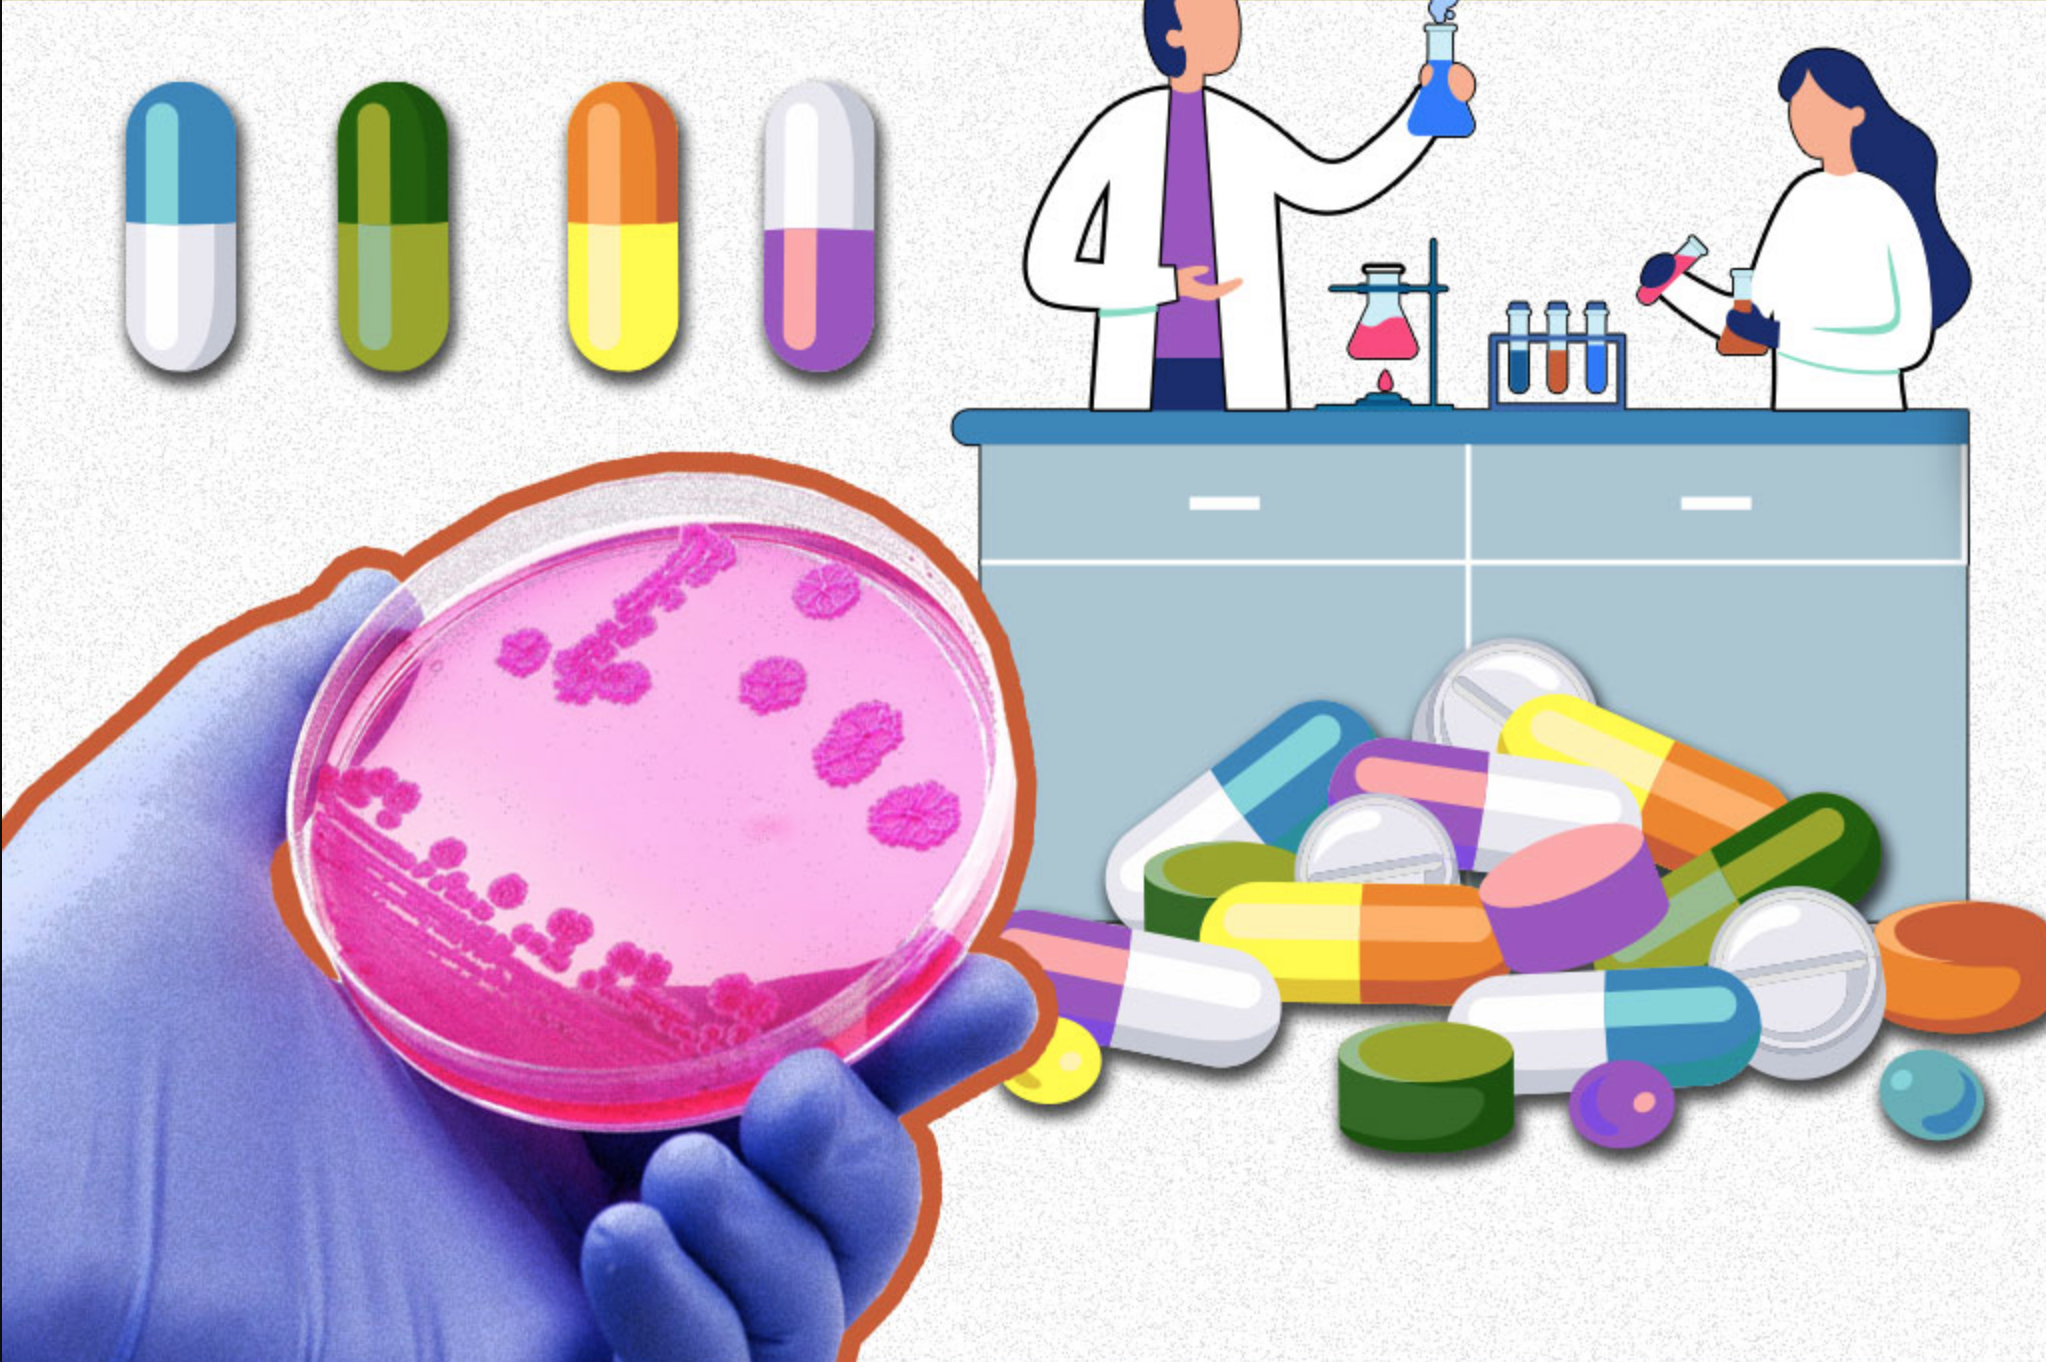

La resistencia antimicrobiana (RAM) es una de las mayores amenazas para la salud global. Un estudio reciente, publicado en The Lancet, advierte que más de 39 millones de personas podrían morir para el 2050 debido a infecciones que los antibióticos ya no podrán tratar.
Este problema afecta de manera desproporcionada a los mayores de 70 años, quienes son los más vulnerables.
El estudio, realizado por el Proyecto de Investigación Global sobre Resistencia a los Antimicrobianos (GRAM), estima que más de un millón de personas murieron anualmente por infecciones resistentes entre 1990 y 2021.
Si no se toman medidas urgentes, las muertes podrían aumentar un 70% en las próximas décadas, con 1,91 millones de fallecimientos por año.
¿Qué es la resistencia a los antibióticos?
La RAM ocurre cuando bacterias y otros patógenos evolucionan y se vuelven inmunes a los tratamientos existentes.
Enfermedades comunes, como la neumonía o infecciones postoperatorias, podrían volverse nuevamente mortales.
La situación es especialmente grave en regiones como el norte de África y Oriente Medio, donde se espera un aumento del 234% en las muertes relacionadas con RAM.
Los expertos, como el Dr. Mohsen Naghavi, investigador del Instituto de Métricas de Salud (IHME), y el Dr. Luis Ostrosky, de UTHealth Houston, coinciden en que es necesario mejorar el acceso a antibióticos y desarrollar nuevos tratamientos.
La Organización Mundial de la Salud (OMS) también ha clasificado la resistencia a antibióticos como una de las principales amenazas para la humanidad.
Sin acciones inmediatas, el mundo podría entrar en una era posantibiótica, donde las infecciones bacterianas ya no responderán a los medicamentos actuales, poniendo en riesgo décadas de avances médicos.
También lee:
El 15% de los mexicanos sufre migraña ¿qué es?
Alan Wake 2 no presenta mejoras significativas en PS5 Pro